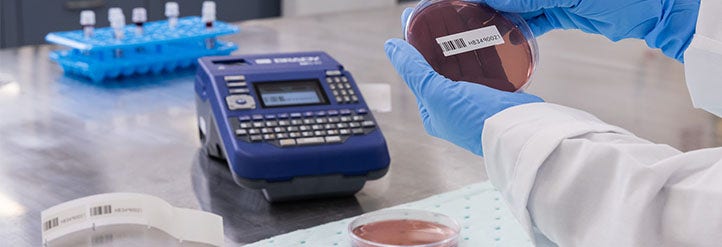
Portable Label Printers

- Top Categories
- Products
- Promotions
- Applications
- Resources
Top Categories

Brady Custom Label Request
Request a custom label specific to your needs.
Featured Products
Product Showcases
All Products
Promotions
- Sample Identification
- On-Site Label Creation
- Sample ID Automation
- Safety
Sample Identification
Laboratory Identification Challenges
Loss means different things across various types of lab, from a minor inconvenience to major devastation:
- In clinical settings, it can lead to misdiagnoses, delays in diagnoses or even fatalities and lawsuits
- In pharmaceutical environments, it can postpone or halt drug development and production
- In academic laboratories, it can impair or even void your findings
- In biotechnology settings, it can compromise your quality control, data integrity or drug safety. It also opens the door for the possibility of intellectual property loss or a delay in technology and product development
On-Site Label Creation
Brady printers enable professionals to print highly specialised identification labels on-site and on demand. Partnered with customisable software and a specific application system for laboratories, which is adaptable to specific processes or data file formats, Brady printers support considerable time savings and flexibility in sample identification. Every Brady identification label can be printed on-site using a Brady mobile or benchtop printer. Brady also offers barcode scanners that can meet the needs of a variety of tracking applications including: basic data entry, electronics, lab, shipping and receiving, WIP, and more.
Sample ID Automation
Brady's printer applicators offer an automated solution to applying print-on-demand labels to circuit boards, wire and cable, and a variety of other products. Brady also offers barcode scanners that can meet the needs of a variety of tracking applications including: basic data entry, electronics, lab, shipping and receiving WIP, and more.
Safety
Proper identification helps ensure safety at work and maximizes productivity, both indoors and outdoors. Find all the safety signs you need with Brady.
Other offerings include spill control and area marking (traffic safety) products, as well as visual tagging or lockout/tagout systems.
Helpful Resources
Videos
M410 Label Printer
The M410 Label Printer is an everyday workhorse for DataCom, electrical, and lab professionals.
M510 Label Printer
All-day power. Every day durability.
M611 Label Printer
Flexibility at work. Design. Preview. Print. Any way you choose.
BBP12 Label Printer
The compact BBP12 offers a high print speed of 100 mm/second and can handle a wide range of highly durable and specialized Brady identification labels.
BradyJet J7300 Color Label Printer
Efficient DIY full-color 10 cm printing for lab, chemical, and product identification. Hassle-free and reliable.
BradyPrinter i7100 Industrial Label Printer
Automate vial tube identification to increase the output of your laboratory.
Brady Workstation Software Apps
Overview video for Brady Workstation software apps and suites.

About Brady Corporation
Brady Corporation is an international manufacturer and marketer of complete solutions that identify and protect people, products, and places.
At Brady, committment to performance drives our business decisions every day. We design our products and solutions to perform in ways that others simply don't. Our people perform in ways that regularly exceed expectations and our focus and discipline as a company works toward solid, long-term performance for our customers and shareholders. In short, the essence of Brady and subsequently our brand is centered on "performance".
Available Programs